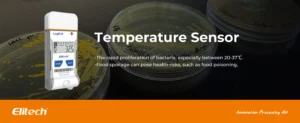

LogEt 5
Designed for Multiple Scenarios Temperature Monitor

Auto-generated PDF & CSV

Shortcut Buttons

Shadow Data

Indication Instruction

Temperature Sensor

Humidity Sensor

All products in LogEt 5 series

LogEt 8

Auto-generated PDF Report

Temperature Sensor
Humidity Sensor

MKT Value


Buttons

High-Precision Sensor





















































